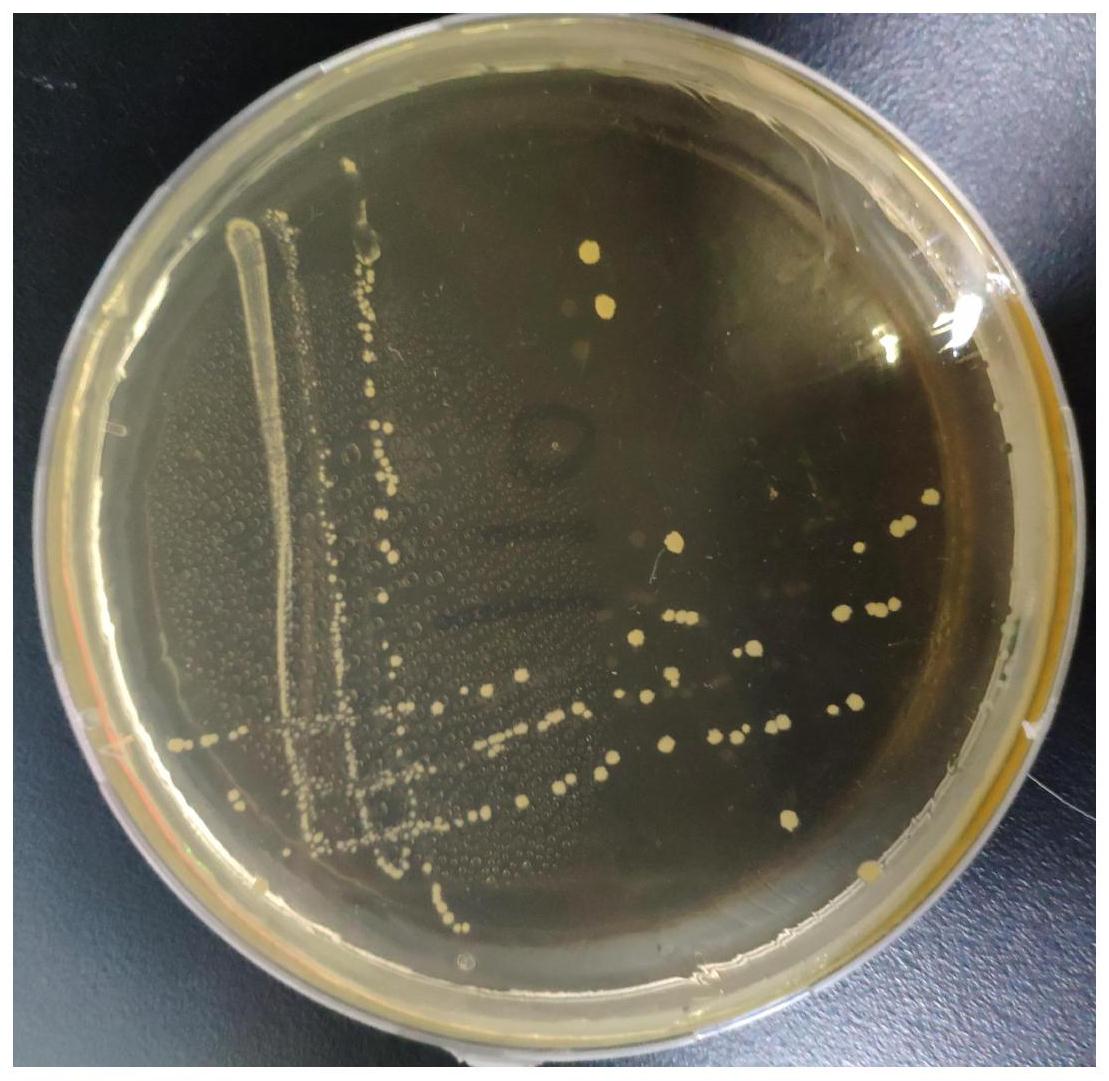
一种副干酪乳杆菌及其在宠物犬犬粮中的应用

乳杆菌图片

保加利亚乳杆菌pzlb5-内蒙古普泽生物制品有限责任公司
图片尺寸542x308
希氏乳杆菌在农业种植领域将广泛应用
图片尺寸550x413
乳酸杆菌的历史渊源
图片尺寸268x346
植物乳杆菌|北纳生物
图片尺寸734x473
显微镜观察酸奶中的乳酸菌放大1600倍的乳酸菌
图片尺寸1080x1920
植物乳杆菌的生理功能
图片尺寸350x263
保加利亚乳杆菌图片
图片尺寸459x612
植物乳杆菌对蘑菇的保鲜作用及机理一
图片尺寸711x455
瑞士乳杆菌_广东益可维生物技术有限公司
图片尺寸600x600
一种降低乳蛋白抗原性的植物乳杆菌
图片尺寸1006x1077
乳杆菌图片
图片尺寸612x408
比较基因组学揭秘食草动物肠道中罗伊氏乳杆菌的遗传多样性和生境
图片尺寸800x600
乳杆菌图片
图片尺寸612x459
常用于发酵酸奶的保加利亚乳杆菌扫描电镜图
图片尺寸322x211
乳杆菌图片
图片尺寸612x473
乳杆菌图片
图片尺寸612x459
保加利亚乳杆菌的形态及染色
图片尺寸600x450
保加利亚乳杆菌图片
图片尺寸612x408
一种副干酪乳杆菌及其在宠物犬犬粮中的应用
图片尺寸1109x1081
约氏乳杆菌
图片尺寸800x600
猜你喜欢:嗜酸乳杆菌图片乳酸杆菌图片乳杆菌乳杆菌活菌胶囊图片植物乳杆菌图片双歧杆菌图片肠杆菌图片植物乳杆菌布氏乳杆菌罗伊氏乳杆菌图片发酵乳杆菌瑞士乳杆菌唾液乳杆菌干酪乳杆菌嗜酸乳杆菌副干酪乳杆菌植物乳杆菌粉双歧杆菌颗粒图片植物乳杆菌购买保加利亚乳杆菌乳杆菌活菌胶囊的作用植物乳杆菌299v植物乳杆菌菌落形态植物乳杆菌p9植物乳杆菌掌元罗伊氏乳杆菌植物乳杆菌lp45植物乳杆菌s58鼠李糖乳杆菌早上好图片最新图片九九乘法表 背快水彩画公园橱柜高度一般多少迪士尼玩偶头像redwing8111搭配怪盗基德手绘 手帐台湾叶青个人资料nba头像 一两符文图案 图标男人JJ真人 头像坚果礼盒文案1500元微信红包图片